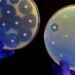
Diseñan una vacuna para combatir la resistencia a los antibióticos

Los carriles en sentido Torremolinos de la avenida Antonio Machado de Benalmádena Costa podrán registrar retenciones de tráfico a partir de este próximo lunes, 13 de mayo, a la altura del hotel Tritón, toda vez que el carril derecho será ocupado para la realización de trabajos de sustitución de la red de pluviales.
En este sentido han informado desde el Consistorio en un comunicado, en el que señalan que las obras tienen una duración estimada de entre tres y cuatro semanas.
Desde la Policía Local, y con el conocimiento de ser esta una arteria fundamental que conecta con los municipios vecinos y el Puerto, se solicita a la ciudadanía que opte por vías alternativas para evitar en la medida de lo posible retenciones por la utilización de un carril, utilizando, entre otras vías, la avenida García Lorca en dirección a la autovía en vez de bajar hacia la costa para evitarlas.